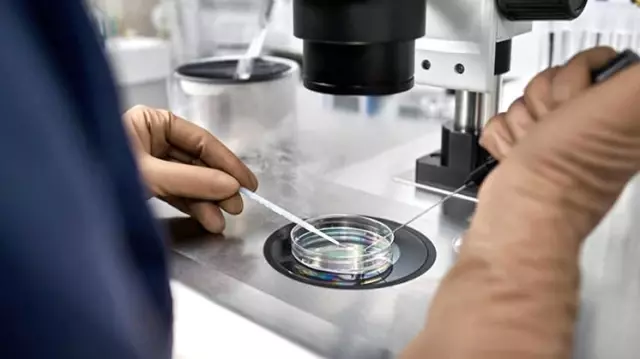

Gitgide artan sayıda bayan çeşitli nedenlerle yumurtalarını donduruyor. Bununla birlikte, yumurtalarını müdafaayı düşünen bayanlar için çok az yol gösteren kaynak var.
36 YAŞINDAN EVVEL DONDURUN
Daha evvel dondurulmuş yumurtalardan en yüksek canlı doğum oranlarının, 30 yaşından evvel bu süreci yaptıran bayanların yumurtalarından alındığı görülmüştür. Lakin, bayanların yumurtalarını dondurdukları yaş ortalaması, birçok bayan için 30’larının sonları ve 40’lı yılların başıdır.
Gelecekte olacak bir doğum için en düzgün muvaffakiyet talihine sahip olmak için, 36 yaşından evvel yumurtalarınızı dondurmanız en güzeli olacaktır. Bu sayede sakladığınız yumurtalar dondurulma süreciyle kâfi kalitede kalır ve bu yumurtaları gelecekte kullanabilirsiniz.
YUMURTALAR TÜRKİYE‘DE YALNIZCA 5 YIL SAKLANABİLİYOR
Türkiye‘deki yasal düzenlemeler, yumurtaların yalnızca 5 yıl donmuş olarak kalmasına müsaade veriyor.
KAÇ ADET YUMURTA DONDURMALIYIM?
Dondurduğunuz yumurta ne kadar çoksa ve yumurtalar kaliteli olduğu sürece, gelecekte canlı bir doğum yapma olasılığınız o kadar yüksek olur. Son datalar, 34 yaşındaki bir bayanın yüzde 75 oranda canlı doğum talihine sahip olması için 10 yumurtayı dondurması gerektiğini ileri sürüyor. Lakin 37 yaşında bu süreci yaptıran bir bayanın 20 yumurtayı dondurması gerekirken, 42 yaşındaki bir bayanın birebir muvaffakiyet bahtına sahip olması için 61 yumurtayı dondurması gerekiyor.
YUMURTA DONDURMA NE KADARA MALOLUR?
Türkiye’de yumurta toplama ve dondurma masrafları 7-10 bin TL civarındadır. Yumurtaları depolama maliyetleri ise ekstradır. Bunun fiyatı yılda ortalama 900 liradır.
TECRÜBELİ BİR KLİNİĞE BAŞVURUN
Yumurtalarınızı dondurmayı düşünüyorsanız, prosedürle ilgili çok fazla tecrübeye sahip bir klinik bulun. Kliniğe, yumurta dondurma sürecindeki muvaffakiyet oranları ve bunu nasıl sağladıklarıyla ilgili sorular sorun.